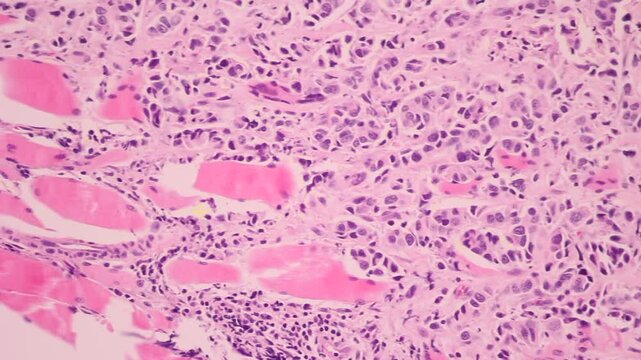
View in microscopic of glandular epithelial cell, adenonocarcinoma from human lung cancer, tissue section by H and E stain.Pathology diagnosis.Medical concept. Under microscope, magnification 600X

Erstellen ohne Grenzen – unbegrenzte Downloads plus leistungsstarke KI-Bearbeitung.
Erstellen ohne Grenzen – unbegrenzte Downloads plus leistungsstarke KI-Bearbeitung.
Neue Filter hinzugefügt
Sortieren nach
229 Ergebnisse für squamous in „Videos“
Region wählen
Durch Auswahl einer Region können sich die Sprache und die Werbeinhalte auf der Adobe Stock-Website ändern.
Nordamerika
Südamerika
- Venezuela
- Algeria - English
- Armenia - English
- Azerbaijan - English
- Bahrain - English
- Belgium - English
- Belgique - Français
- België - Nederlands
- Česká republika
- Croatia - English
- Cyprus - English
- Danmark
- Georgia - English
- Deutschland
- Eesti
- Egypt - English
- España
- France
- Greece - English
- Iceland - English
- Ireland
Europa, Naher Osten und Afrika
- Israel - English
- Italia
- Jordan - English
- Казахстан
- Kenya - English
- Kuwait - English
- Киргизия
- Latvija
- Lebanon - English
- Lietuva
- Luxembourg - Deutsch
- Luxembourg - English
- Luxembourg - Français
- Mauritius - English
- Moldova - English
- Hungary - English
- Malta - English
- Morocco - English
- Nederland
- Nigeria
- Norge
- Oman - English